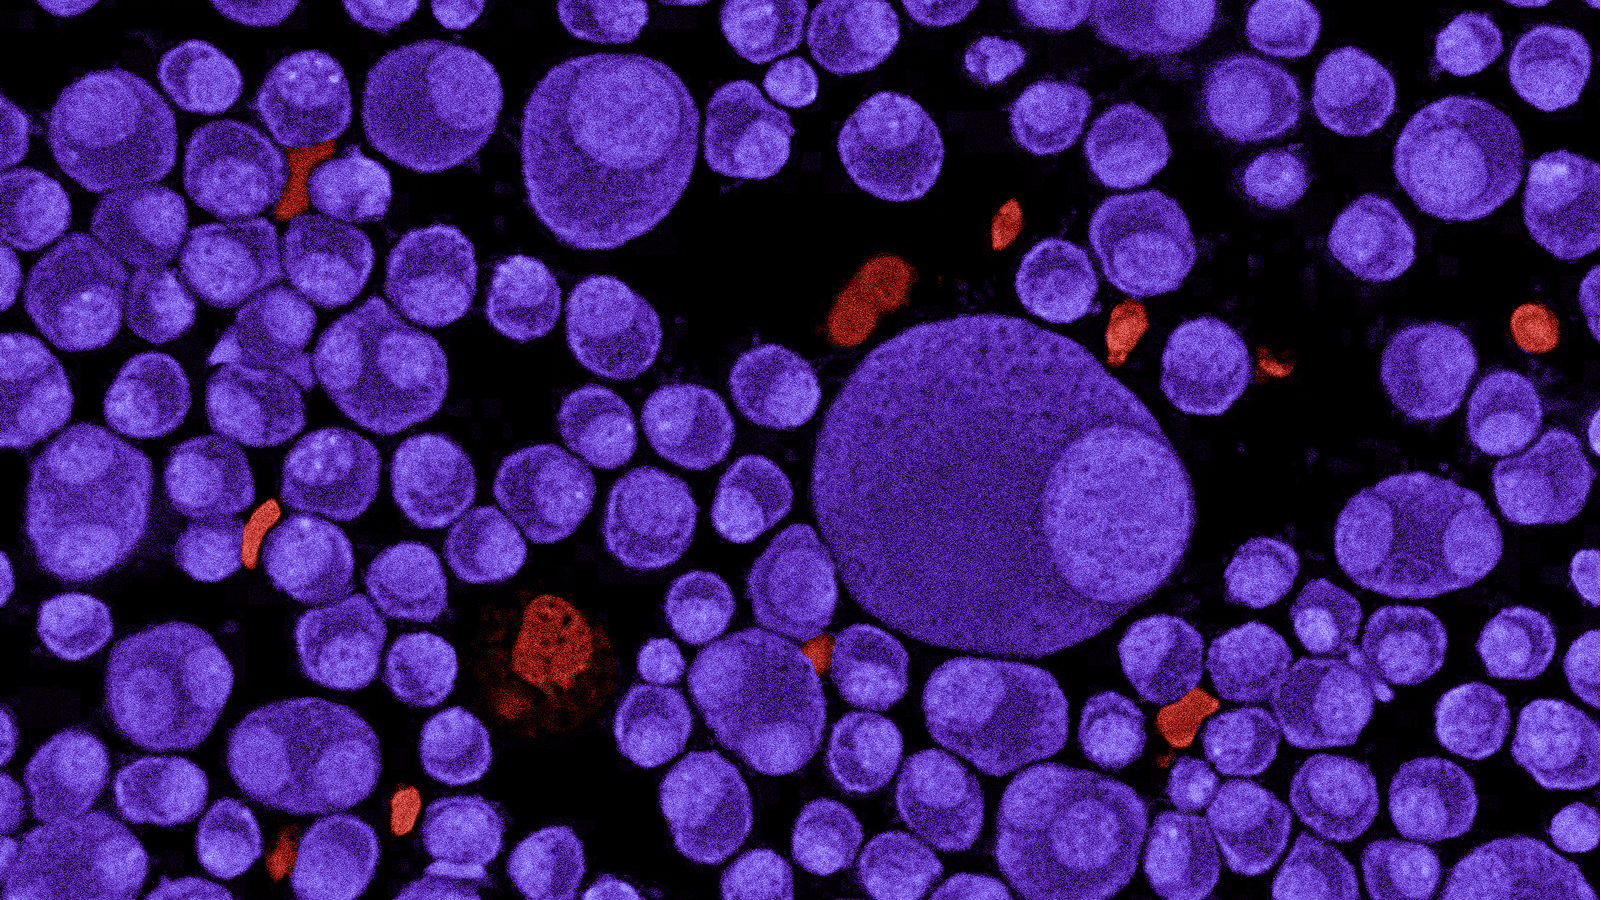
CAR T-cell Therapy for Multiple Myeloma

GoCART
GoCART Therapeutics is building a new generation of safer, smarter cell therapies for cancer. Our technology uses a biological 'AND-gate'—a two-key safety system that only activates its 'kill' signal when it detects two distinct targets on a cancer cell. This logic-gated approach dramatically reduces the toxicity risks of current CAR-T therapies.
Community Sentiment
How do you feel about this ipt?

Community Sentiment
How do you feel about this ipt?
Project
Market Overview
Additional Documentation
Summary
GoCART pushes the frontier of DeSci by demonstrating how decentralized, community-driven funding can accelerate the development of complex, high-impact synthetic biology IP. Scientifically, we are moving beyond single-target therapies to a new paradigm of programmable, "smart" cell therapies that can address the inherent complexity of cancer, which has been the primary blocker for treating most cancers with cell therapy.
Problem
Existing CAR-T cell therapies, while revolutionary for some blood cancers, **fail to succeed outside of a narrow set of cancer types** and suffer from severe "on-target, off-tumor" toxicity. This is due to cancer antigens often being shared with healthy cells, leading to life-threatening side effects (e.g., cytokine release syndrome, neurotoxicity) and antigen escape, where tumors evade single-target therapies. The fundamental problem is a lack of precision, safety, and adaptability.
Impact
GoCART's solution is a novel **AND-gate CAR-T design** that incorporates logic. Our engineered T-cells activate _only_ when they detect _multiple_ specific cancer antigens simultaneously on a target cell. This significantly enhances specificity, mitigates off-target toxicity, and reduces antigen escape. Our edge lies in this modular, tunable logic-gating system that enables safer, more effective CAR-T therapies with broad applicability beyond existing limitations.
Market Overview
Additional Documentation
Summary
GoCART pushes the frontier of DeSci by demonstrating how decentralized, community-driven funding can accelerate the development of complex, high-impact synthetic biology IP. Scientifically, we are moving beyond single-target therapies to a new paradigm of programmable, "smart" cell therapies that can address the inherent complexity of cancer, which has been the primary blocker for treating most cancers with cell therapy.
Problem
Existing CAR-T cell therapies, while revolutionary for some blood cancers, **fail to succeed outside of a narrow set of cancer types** and suffer from severe "on-target, off-tumor" toxicity. This is due to cancer antigens often being shared with healthy cells, leading to life-threatening side effects (e.g., cytokine release syndrome, neurotoxicity) and antigen escape, where tumors evade single-target therapies. The fundamental problem is a lack of precision, safety, and adaptability.
Impact
GoCART's solution is a novel **AND-gate CAR-T design** that incorporates logic. Our engineered T-cells activate _only_ when they detect _multiple_ specific cancer antigens simultaneously on a target cell. This significantly enhances specificity, mitigates off-target toxicity, and reduces antigen escape. Our edge lies in this modular, tunable logic-gating system that enables safer, more effective CAR-T therapies with broad applicability beyond existing limitations.
AI Trimer Generation
In Silico design with Genki IT
Binder Discovery
VHH generation with ONCERA/WuXi
Candidate Optimization
Finalizing 1–4 trimer candidates
CAR Vector Establishment
Retroviral vector design & delivery
Foundational Patents
Filing IP for Trimer sequence composition
In Vitro Validation
Primary Proof-of-Concept via cytotoxicity assays

Programming CAR T Cell Tumor Recognition: Tuned Antigen Sensing and Logic Gating
https://doi.org/10.1158/2159-8290.cd-23-0101

Scientists are making CAR-T cells more clever. Here’s what the next generation could look like
https://statnews.com/2022/01/14/cancer-cart-cell-therapy-research

Virtual Event: CAR-T comes of age?
https://statnews.com/2021/10/14/virtual-event-car-t-comes-of-age

Switchable’ CAR-T startup raises $112 million
https://statnews.com/2024/10/22/biotech-news-pfizer-eli-lilly-avencell-editas-car-t-takeda-biomarin-the-readout
CAR T-cell Therapy for Multiple Myeloma
https://cancer.org/cancer/types/multiple-myeloma/treating/car-t-cell-therapy.html

Patient-reported efficacy and toxicity in CAR T-cell therapy for multiple myeloma via Internet-based platforms
https://asco.org/abstracts-presentations/ABSTRACT340495
Community
Stay up to date
Get the latest community updates and find out about upcoming GoCART developments